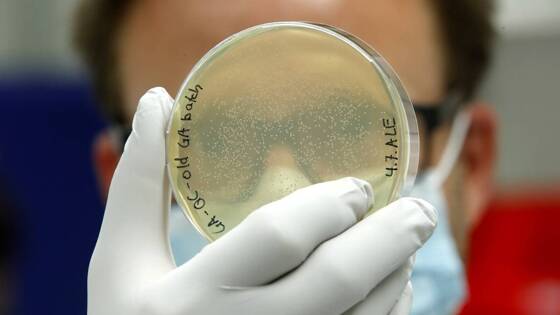

Обнаружена уязвимость у опасной бактерии
Ученые Университета Южной Дании обнаружили уязвимость опасной бактерии Pseudomonas aeruginosa, устойчивой к антибиотикам. Результаты исследования опубликованы в журнале Microbiology Spectrum.
Специалисты обнаружили механизм, уменьшающий образование биопленки на поверхности P. aeruginosa. Биопленка представляет собой толстую слизистую оболочку, которая защищает бактерии от антибиотиков, предотвращая их проникновение внутрь клетки.
Исследователи изучили влияние на резистентность трех недавно обнаруженных генов в штамме P. aeruginosa, выращенном в лаборатории. Сверхэкспрессия этих генов привела к значительному сокращению биопленки. При этом система, к которой относятся эти гены, является частью основного генома бактерии, что делает ее характерной для всех известных штаммов патогенного микроорганизма, в том числе тех, что выделены из организма пациентов.
Кроме того, ученые обнаружили, что эта система естественным образом стимулируется стрессовыми факторами, влияющими на клеточную стенку. Это открытие может быть использовано для разработки препаратов, которые нагружают клеточную стенку и тем самым уменьшают образование биопленки, облегчая проникновение антибиотиков в клетку.